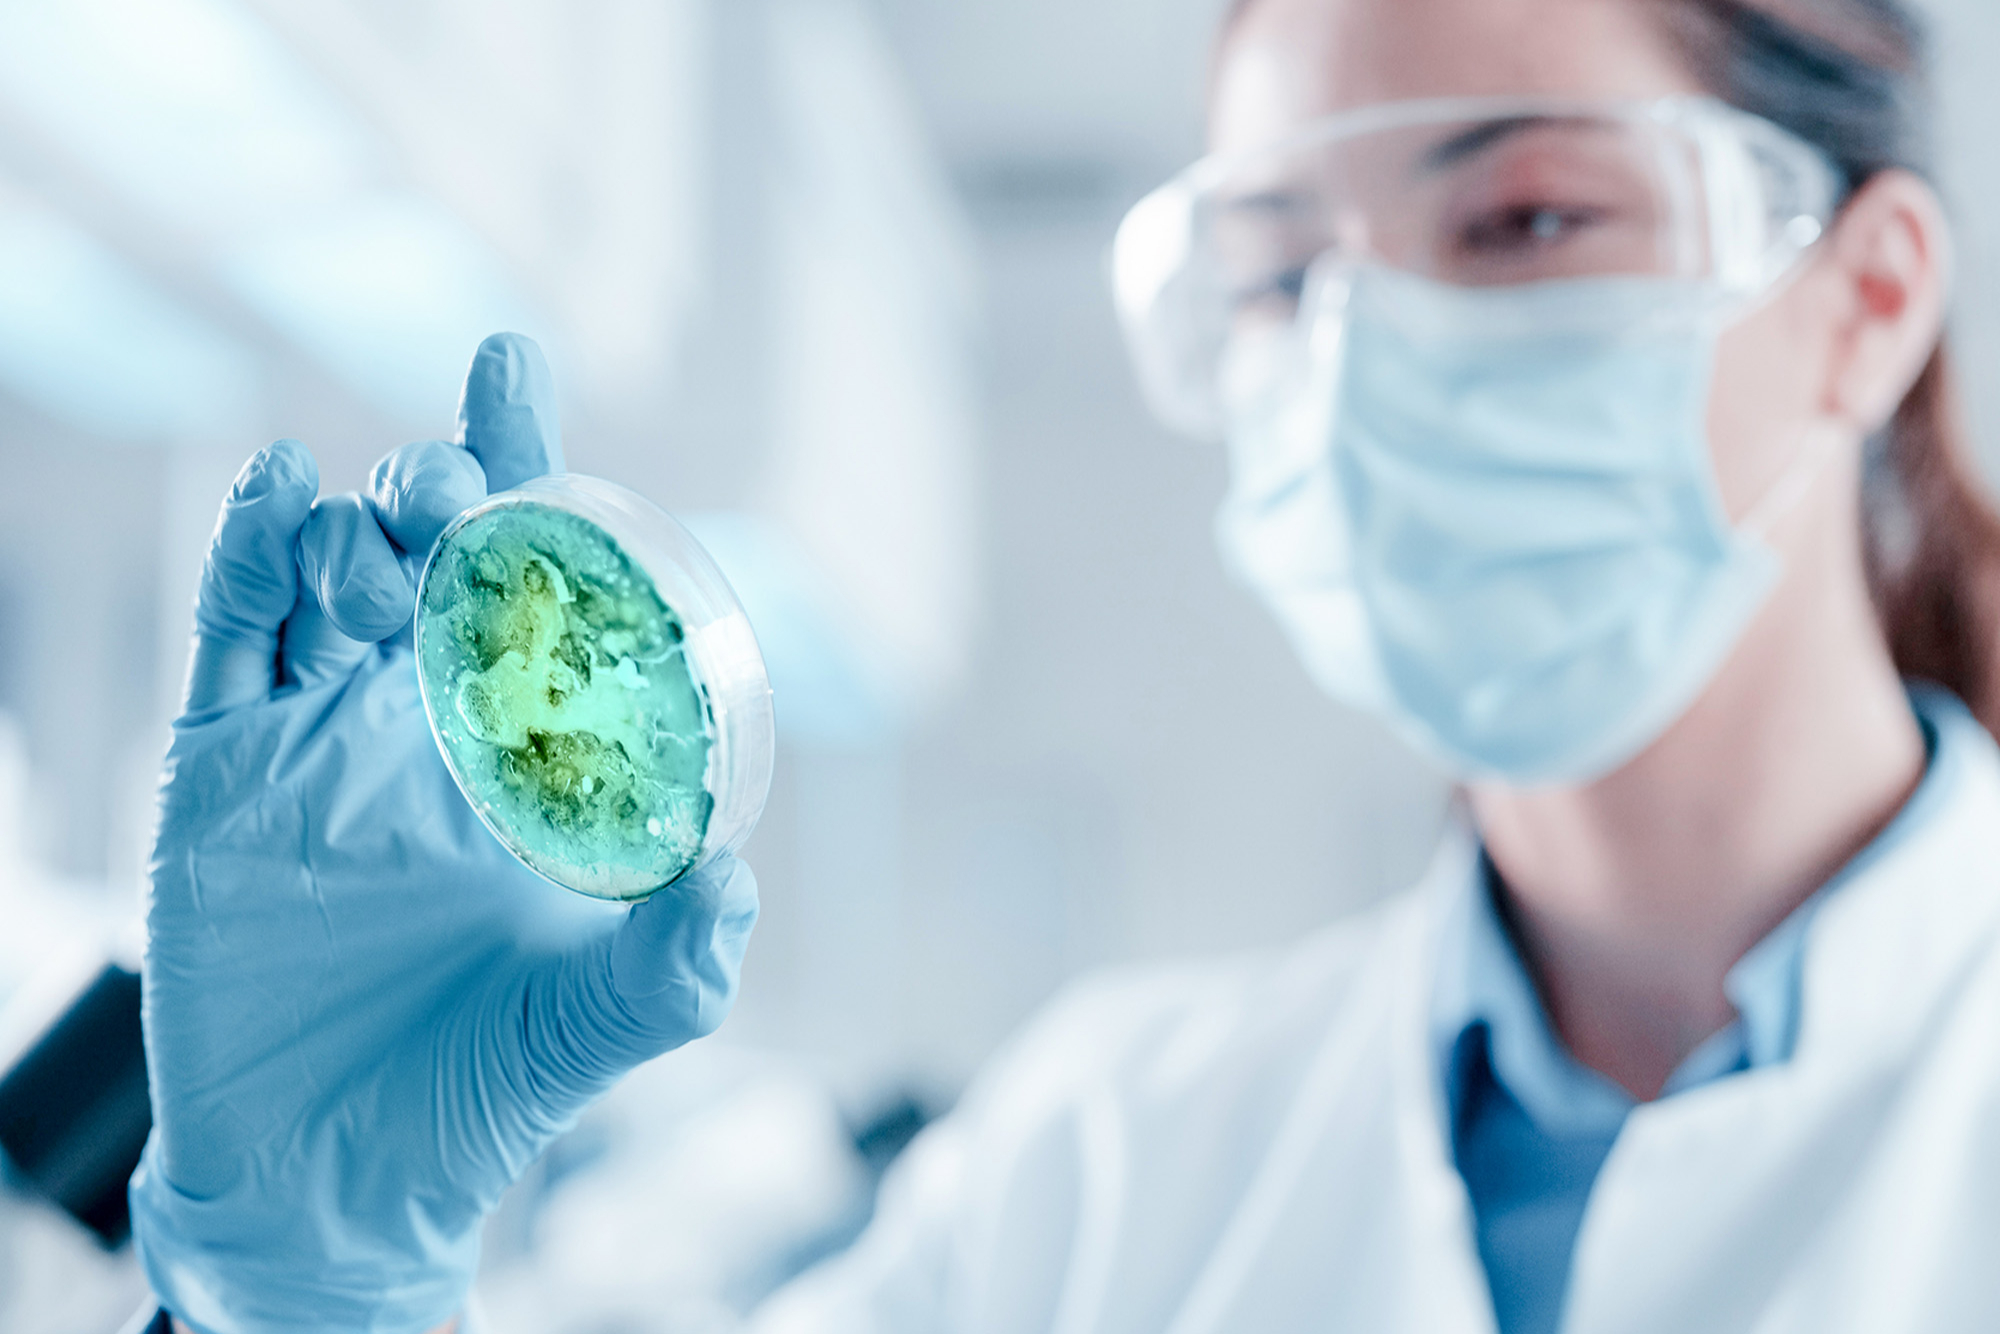

Our innovations are used in products applied in everyday life.
We divide this type of imagery into images created in a natural environment and studio setting. At the heart of our mission is the creation of materials that enhance lives while promoting sustainability within our communities. In our imagery, we aim to capture the essence of this vision, showcasing the transformative power of our products and processes. Every application and setting depicted in our photos reflects the innovative character of our brand, illustrating a future that is both aspirational and achievable.
Studio applications style guide
These images show the applications, in which our solutions are used, as they are in a neutral, clean environment. Photography as well as CGI can be used to create these images. CGI can be useful when creating images for fields in which no particular brands can be shown or to make futuristic applications.
Composition
The product is the hero of the image and the composition emphasizes the characteristics of the product. These can be close-ups or images where they are completely visible. Exploded views where our solutions are visible can be used too.
Setting
The environment is neutral and clean.
Lighting
Preferably we only use a single neutral-colored light source that emphasizes the application features.
Color & Styling
The only color visible is that of the applications themselves. No extra elements are added.
Do's & Don'ts

Environmental applications style guide
The focus of these images is the products, in which our solutions are being used, in use. They are created through photography. It is also an option to use CGI here. For example, if we wanted to show a car in the scene but could not show the car brand, we could create a car in CGI and add it to the scene. The benefit of this is also that we can customize the look and style of the car to suit our brand.
Composition
The focus of the images should always be the product together with one or more people. Both are equally important. We play with interesting angles, depth of field, and light. The person doesn’t always have to be recognizable or completely visible in the frame.
Setting
We create the images in the environment where they would naturally appear. This can be an indoor setting, like an office or a home, or an outdoor setting. When shooting outdoors, make sure nature is always visible. Never shoot in industrial or urban environments.
Lighting
The images use warm natural, or naturally looking, light. Soft, low warm lighting is used to create interesting shadows and depth in the image.
Color & Styling
The styling of the environment feels warm, cozy, and contemporary. The styling of the models should complement the environment and for example, wear warm or blue tones. The clothing is rather casual and never grabs the attention.
Do's & Don'ts















